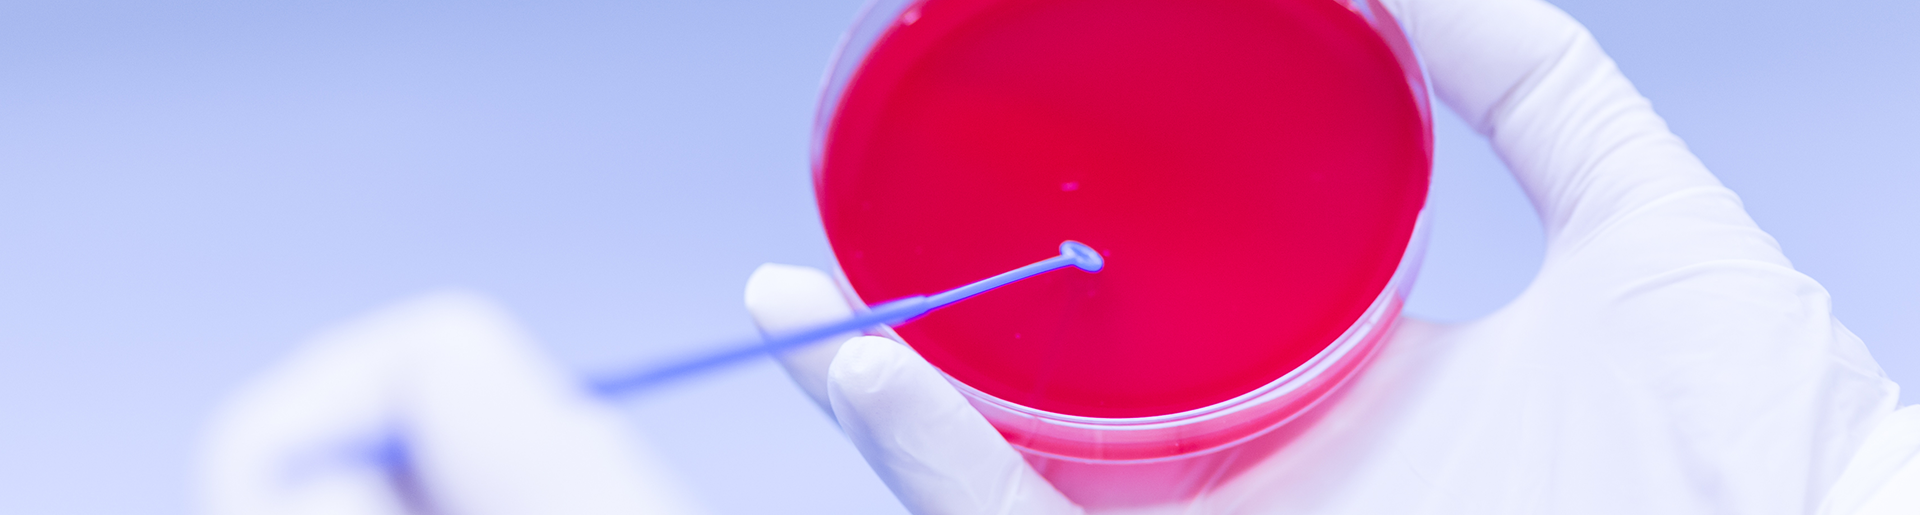

Αιματολογία
Α' Αιματολογική Κλινική
Η Αιματολογική Κλινική δραστηριοποιείται διερευνητικά, διαγνωστικά, θεραπευτικά σε όλους τους τομείς της Κλινικής και Εργαστηριακής Αιματολογίας, καθώς και στην παρακολούθηση όλων των νοσημάτων του αίματος και, κυρίως, τις αιματολογικές κακοήθειες.
Τηλέφωνο:210-6972489 Τηλεφωνικό Κέντρο:210-6972000
ΔΕΙΤΕ ΑΝΑΛΥΤΙΚΑ